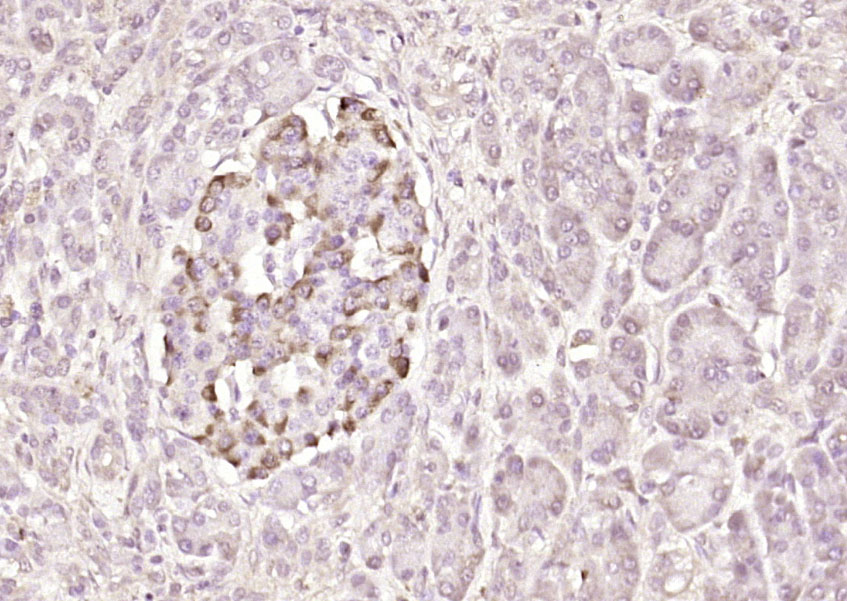
PIK3R5 Rabbit pAb(bs-7467R)-50

相关产品推荐更多 >

human CD24 Mouse mAb, PE conjugated(bsm-30024M-PE)-25T/50T/100T
¥1580
phospho-GSK3B (Ser9) Rabbit pAb(bs-25483R)-50ul/100ul
¥1180
5HT3A Receptor Rabbit pAb, AP conjugated(bs-12051R-AP)-100ul
¥2980
Puratrophin 1 Rabbit pAb, Biotin conjugated(bs-11747R-Bio)-100ul
¥2980
phospho-c-Jun (Thr93) Rabbit pAb, BF555 conjugated(bs-12913R-BF555)-100ul
¥2980
万千商家帮你免费找货
0 人在求购买到急需产品
- 详细信息
- 技术资料
- 应用范围:
产品信息以Bioss网站为准
- 规格:
50ul/100ul/200ul
| 规格: | 50ul | 产品价格: | ¥1180.0 |
|---|---|---|---|
| 规格: | 100ul | 产品价格: | ¥1980.0 |
| 规格: | 200ul | 产品价格: | ¥2800.0 |
| 产品编号 | bs-7467R |
| 英文名称 | PIK3R5 Rabbit pAb |
| 中文名称 | 磷脂酰肌醇激酶催化亚单位p101抗体 |
| 英文别名 | PIK3R5; PIK3 R5; PI 3-kinase p101; PI3K p101; PI3R5_HUMAN; phosphoinositide 3-kinase regulatory subunit 5; PI3-kinase regulatory subunit 5; PI3-kinase p101 subunit; Phosphatidylinositol 4, 5-bisphosphate 3-kinase regulatory subunit; PtdIns-3-kinase regulatory subunit; Protein FOAP-2; PtdIns-3-kinase p101; p101-PI3K; p101-PI3K; FOAP 2; FOAP2. |
| 产品应用 | IHC-P=1:100-500, IHC-F=1:100-500, IF=1:100-500 Not yet tested in other applications. |
| 交叉反应 | Human, Mouse (Rat, Pig, Cow, Horse, Rabbit, Sheep) |
| 抗体来源 | Rabbit |
| 免疫原 | KLH conjugated synthetic peptide derived from human PIK3R5 |
| 亚型 | IgG |
| 性状 | Liquid |
| 纯化方法 | affinity purified by Protein A |
| 克隆类型 | Polyclonal |
| 理论分子量 | 97 kDa |
| 浓度 | 1mg/ml |
| 储存液 | 0.01M TBS (pH7.4) with 1% BSA, 0.02% Proclin300 and 50% Glycerol. |
| 亚基 | Heterodimer of a catalytic subunit (PIK3CG/p120) and a regulatory (PIK3R5a/p101) subunit. Interacts with beta-gamma G protein dimers. |
| 亚细胞定位 | Nucleus. Cytoplasm. Membrane; Peripheral membrane protein. |
| 组织特异性 | Ubiquitously expressed with high expression in fetal brain compared to adult brain. Abundant expression is observed in cerebellum, cerebral cortex, cerebral meninges, and vermis cerebelli. |
| 功能 | Regulatory subunit of the PI3K gamma complex. Required for recruitment of the catalytic subunit to the plasma membrane via interaction with beta-gamma G protein dimers. Required for G protein-mediated activation of PIK3CG. |
| 保存条件 | Shipped at 4℃. Store at -20℃ for one year. Avoid repeated freeze/thaw cycles. |
| 注意事项 | This product as supplied is intended for research use only, not for use in human, therapeutic or diagnostic applications. |
| 背景资料 | Phosphatidylinositol 3-kinases (PI3Ks) phosphorylate the inositol ring of phosphatidylinositol at the 3-prime position, and play important roles in cell growth, proliferation, differentiation, motility, survival and intracellular trafficking. The PI3Ks are divided into three classes: I, II and III, and only the class I PI3Ks are involved in oncogenesis. This gene encodes the 101 kD regulatory subunit of the class I PI3K gamma complex, which is a dimeric enzyme, consisting of a 110 kD catalytic subunit gamma and a regulatory subunit of either 55, 87 or 101 kD. This protein recruits the catalytic subunit from the cytosol to the plasma membrane through high-affinity interaction with G-beta-gamma proteins. Multiple alternatively spliced transcript variants encoding two distinct isoforms have been found. [provided by RefSeq, Oct 2011] |
| 应用 | 推荐稀释比例 |
| {IHC-P} | {1:100-500} |
| {IHC-F} | {1:100-500} |
| {IF} | {1:100-500} |

Paraformaldehyde-fixed, paraffin embedded (human gastric carcinoma); Antigen retrieval by boiling in sodium citrate buffer (pH6.0) for 15min; Block endogenous peroxidase by 3% hydrogen peroxide for 20 minutes; Blocking buffer (normal goat serum) at 37°C for 30min; Antibody incubation with (PIK3R5) Polyclonal Antibody, Unconjugated (bs-7467R) at 1:200 overnight at 4°C, followed by operating according to SP Kit(Rabbit) (sp-0023) instructionsand DAB staining.
Paraformaldehyde-fixed, paraffin embedded (human pancreatic carcinoma); Antigen retrieval by boiling in sodium citrate buffer (pH6.0) for 15min; Block endogenous peroxidase by 3% hydrogen peroxide for 20 minutes; Blocking buffer (normal goat serum) at 37°C for 30min; Antibody incubation with (PIK3R5) Polyclonal Antibody, Unconjugated (bs-7467R) at 1:200 overnight at 4°C, followed by operating according to SP Kit(Rabbit) (sp-0023) instructionsand DAB staining.

Paraformaldehyde-fixed, paraffin embedded (mouse cerebellum); Antigen retrieval by boiling in sodium citrate buffer (pH6.0) for 15min; Block endogenous peroxidase by 3% hydrogen peroxide for 20 minutes; Blocking buffer (normal goat serum) at 37°C for 30min; Antibody incubation with (PIK3R5) Polyclonal Antibody, Unconjugated (bs-7467R) at 1:200 overnight at 4°C, followed by operating according to SP Kit(Rabbit) (sp-0023) instructionsand DAB staining.
风险提示:丁香通仅作为第三方平台,为商家信息发布提供平台空间。用户咨询产品时请注意保护个人信息及财产安全,合理判断,谨慎选购商品,商家和用户对交易行为负责。对于医疗器械类产品,请先查证核实企业经营资质和医疗器械产品注册证情况。
技术资料暂无技术资料 索取技术资料
PIK3R5 Rabbit pAb(bs-7467R)-50ul/100ul/200ul
¥1180 - 2800





